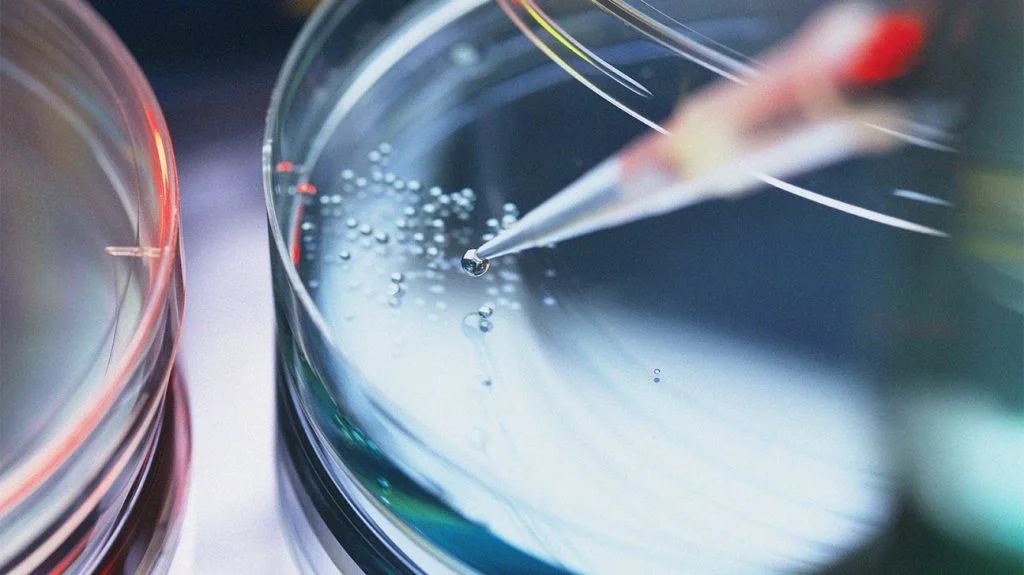

目錄
- 它是否有效?
- 費用和醫療保險
- 臨床試驗
- 風險
- 替代療法
- 摘要
目前,美國食品和藥物管理局(FDA)尚未批準使用干細胞療法來治療肺部疾病,如慢性阻塞性肺病(COPD)。
美國肺臟協會表示,這種缺乏批準的情況是由于這些治療方法成本高,效益未被證實,并有可能造成傷害。
慢性阻塞性肺病是一種漸進式的不治之癥,影響著美國至少1600萬美國人。由于目前的治療方法無法治愈慢性阻塞性肺病,許多患有這種疾病的人尋求替代療法,如干細胞療法。
繼續閱讀,了解更多關于使用干細胞治療慢性阻塞性肺病的潛力,包括成本、臨床試驗和其他。
干細胞治療慢性阻塞性肺病是否有效?
干細胞是來自胚胎或成人的細胞,可以分裂和更新。雖然它們不是特化的,但它們可以變得特化,并最終作為身體各部分的細胞發揮作用。
由于其再生能力和作為不同類型細胞的功能,干細胞可以幫助修復或替換受損組織。科學家們對使用干細胞療法治療幾種慢性疾病感興趣。
然而,大多數研究人員和組織表示,目前還沒有足夠的證據證明干細胞療法的有效性,以及對長期風險的了解。
最近的一份研究摘要顯示,大多數人類研究表明,該療法沒有什么好處。作者指出,研究人員需要進一步了解干細胞療法的許多方面,包括:
- 治療的最佳人選
- 療法的類型,即使用哪些細胞和治療的目的
- 與疾病有關的治療時機
- 劑量問題
換句話說,必須進行更多大規模的研究,以證明或反駁干細胞療法對大多數人的安全性和有效性。
美國肺臟協會與其他許多組織一起簽署了一份聲明,建議反對干細胞治療慢性阻塞性肺病。這些組織的關注點包括:
- 成本
- 潛在的傷害
- 缺乏證據表明該療法對人體有益。
然而,干細胞療法已顯示出一些作為治療方案的潛力。根據美國胸腔協會(ATS),該療法已在動物研究中顯示出前景。ATS還指出,目前仍缺乏足夠的人類研究,因此,除非參與臨床試驗,否則應避免該療法。
國家肺氣腫基金會指出,使用過未經證實的干細胞療法的人,往往愿意接受進一步的輸液,這表明他們有積極的經驗。
最后,泰國再生中心提供并支持使用干細胞療法來治療慢性阻塞性肺病和其他肺部疾病。然而,要接受治療,一個人需要前往泰國,增加了已經潛在的昂貴程序的成本。
費用和醫療保障
由于美國食品和藥物管理局尚未批準干細胞療法用于治療慢性阻塞性肺病,一個人將需要自己承擔所有的費用。他們還需要接受與使用實驗性治療有關的所有風險。
醫療保險和私人保險公司將不會幫助支付這些費用。一個人可能也不能用任何醫療儲蓄賬戶的錢來做這個手術。
價格可能因診所而異,很少有診所(如果有的話)會預先列出治療費用。一家名為DVC Stem的公司在開曼群島提供干細胞治療,并表示治療的平均費用在10,000至35,000美元之間。它建議有興趣接受干細胞治療的人加入臨床試驗。
臨床試驗
臨床試驗是受控實驗,研究人員在一組志愿者中測試一種新的治療方法。這些測試幫助研究人員確定治療的效果如何,可能的副作用,以及理想的劑量,以及其他因素。
臨床試驗分階段進行,每個階段都代表了對治療的信心程度。臨床試驗通常要經過四個階段:信任來源:
- 第一階段:研究人員利用這一階段來判斷治療的副作用,通常招募一小群健康人。
- 第二階段:這一階段通常涉及更大的參與者群體,重點關注治療的療效。
- 第三階段:這一階段需要大群不同的人–從幾百人到幾千人–,考慮療效和安全性。
- 第四階段:該階段發生在美國食品和藥物管理局批準后,評估治療如何影響現實世界中的更大群體。
有興趣加入干細胞治療臨床試驗的人,應先與他們的醫生討論。醫生可以幫助確定他們是否適合某項研究,并可能根據他們的病情和健康狀況推薦一項研究。
ClinicalTrials.gov為人們提供了搜索與COPD和干細胞治療相關的臨床試驗的方法。所列的試驗都是經過批準的,并受到安全監管。該網站列出了有關試驗階段的信息,誰有資格參與,以及其他相關信息。
潛在的副作用和風險
對于干細胞療法的短期和長期副作用,人們的認識有限。換句話說,研究人員有必要進行更多的研究,以準確了解干細胞療法對慢性阻塞性肺病患者的影響。
替代療法
替代性或補充性療法是指不屬于美國醫學常規診療范圍的治療方法。人們通常在接受常規治療的同時接受這些療法,以幫助支持心理健康,減少副作用,并改善生活質量。
美國胸科協會指出,人們可以嘗試幾種治療慢性阻塞性肺病的替代或補充療法。這些療法包括
- 瑜伽、太極拳和其他呼吸練習
- 針灸
- 天然補充劑
- 正念訓練和冥想
概括
干細胞治療慢性阻塞性肺病目前還沒有得到很好的理解。許多研究人員和組織,包括美國肺臟協會,都對該療法的有效性和安全性表示擔憂。
一個人可以從未經批準的診所尋求干細胞治療,但這種治療往往費用很高,而且沒有保險覆蓋。
因此,更好的方法是與醫生討論加入注冊臨床試驗。
參考資料:
- Balkissoon, R. (2018). Stem cell therapy for copd: Where are we? ?
https://www.ncbi.nlm.nih.gov/pmc/articles/PMC6190524/- Chronic obstructive pulmonary disease (COPD). (2021). ?
https://www.cdc.gov/copd/index.html- Complementary therapies for COPD. (2021). ?
https://www.lung.org/lung-health-diseases/lung-disease-lookup/copd/treating/complementary-therapies-copd- Ikonomou, L.,?et al.?(2017). Unproven stem cell treatments for lung disease — an emerging public health problem. ?
https://www.thoracic.org/patients/patient-resources/resources/stem-cell-therapy.pdf- Is lung stem cell therapy for COPD emphysema effective? (2021).?
https://stemcellthailand.org/therapies/copd-chronic-obstructive-pulmonary-disease/- Liang, N.-C.,?et al.?(2017). Integrative medicine (complementary and alternative medicine) for the lungs. ?
https://www.thoracic.org/patients/patient-resources/resources/integrative-medicine.pdf- Statement on unproven stem cell interventions for lung diseases. (2016).
https://www.thoracic.org/members/assemblies/assemblies/rcmb/working-groups/stem-cell/resources/statement-on-unproven-stem-cell-interventions-for-lung-diseases.pdf- Stem cell therapy (advisory). (2021). ?
https://www.lung.org/lung-health-diseases/wellness/public-health-issues-lung-health/stem-cell-therapy- Stem cell therapy for COPD in 2021. (2021). ?
https://www.dvcstem.com/post/stem-cells-copd- Stem cells. (2016).
https://medlineplus.gov/stemcells.html- Stem cells offer new solutions for lung disease. (n.d.). ?
https://www.emphysemafoundation.org/index.php/component/content/article/83-copd-emphysema-articles/338-stem-cells-offer-new-solutions-for-lung-disease- What are clinical trials and studies? (2020).?
https://www.nia.nih.gov/health/what-are-clinical-trials-and-studies免責說明:本文僅用于傳播科普知識,分享行業觀點,不構成任何臨床診斷建議!杭吉干細胞所發布的信息不能替代醫生或藥劑師的專業建議。如有版權等疑問,請隨時聯系我。
掃碼添加官方微信